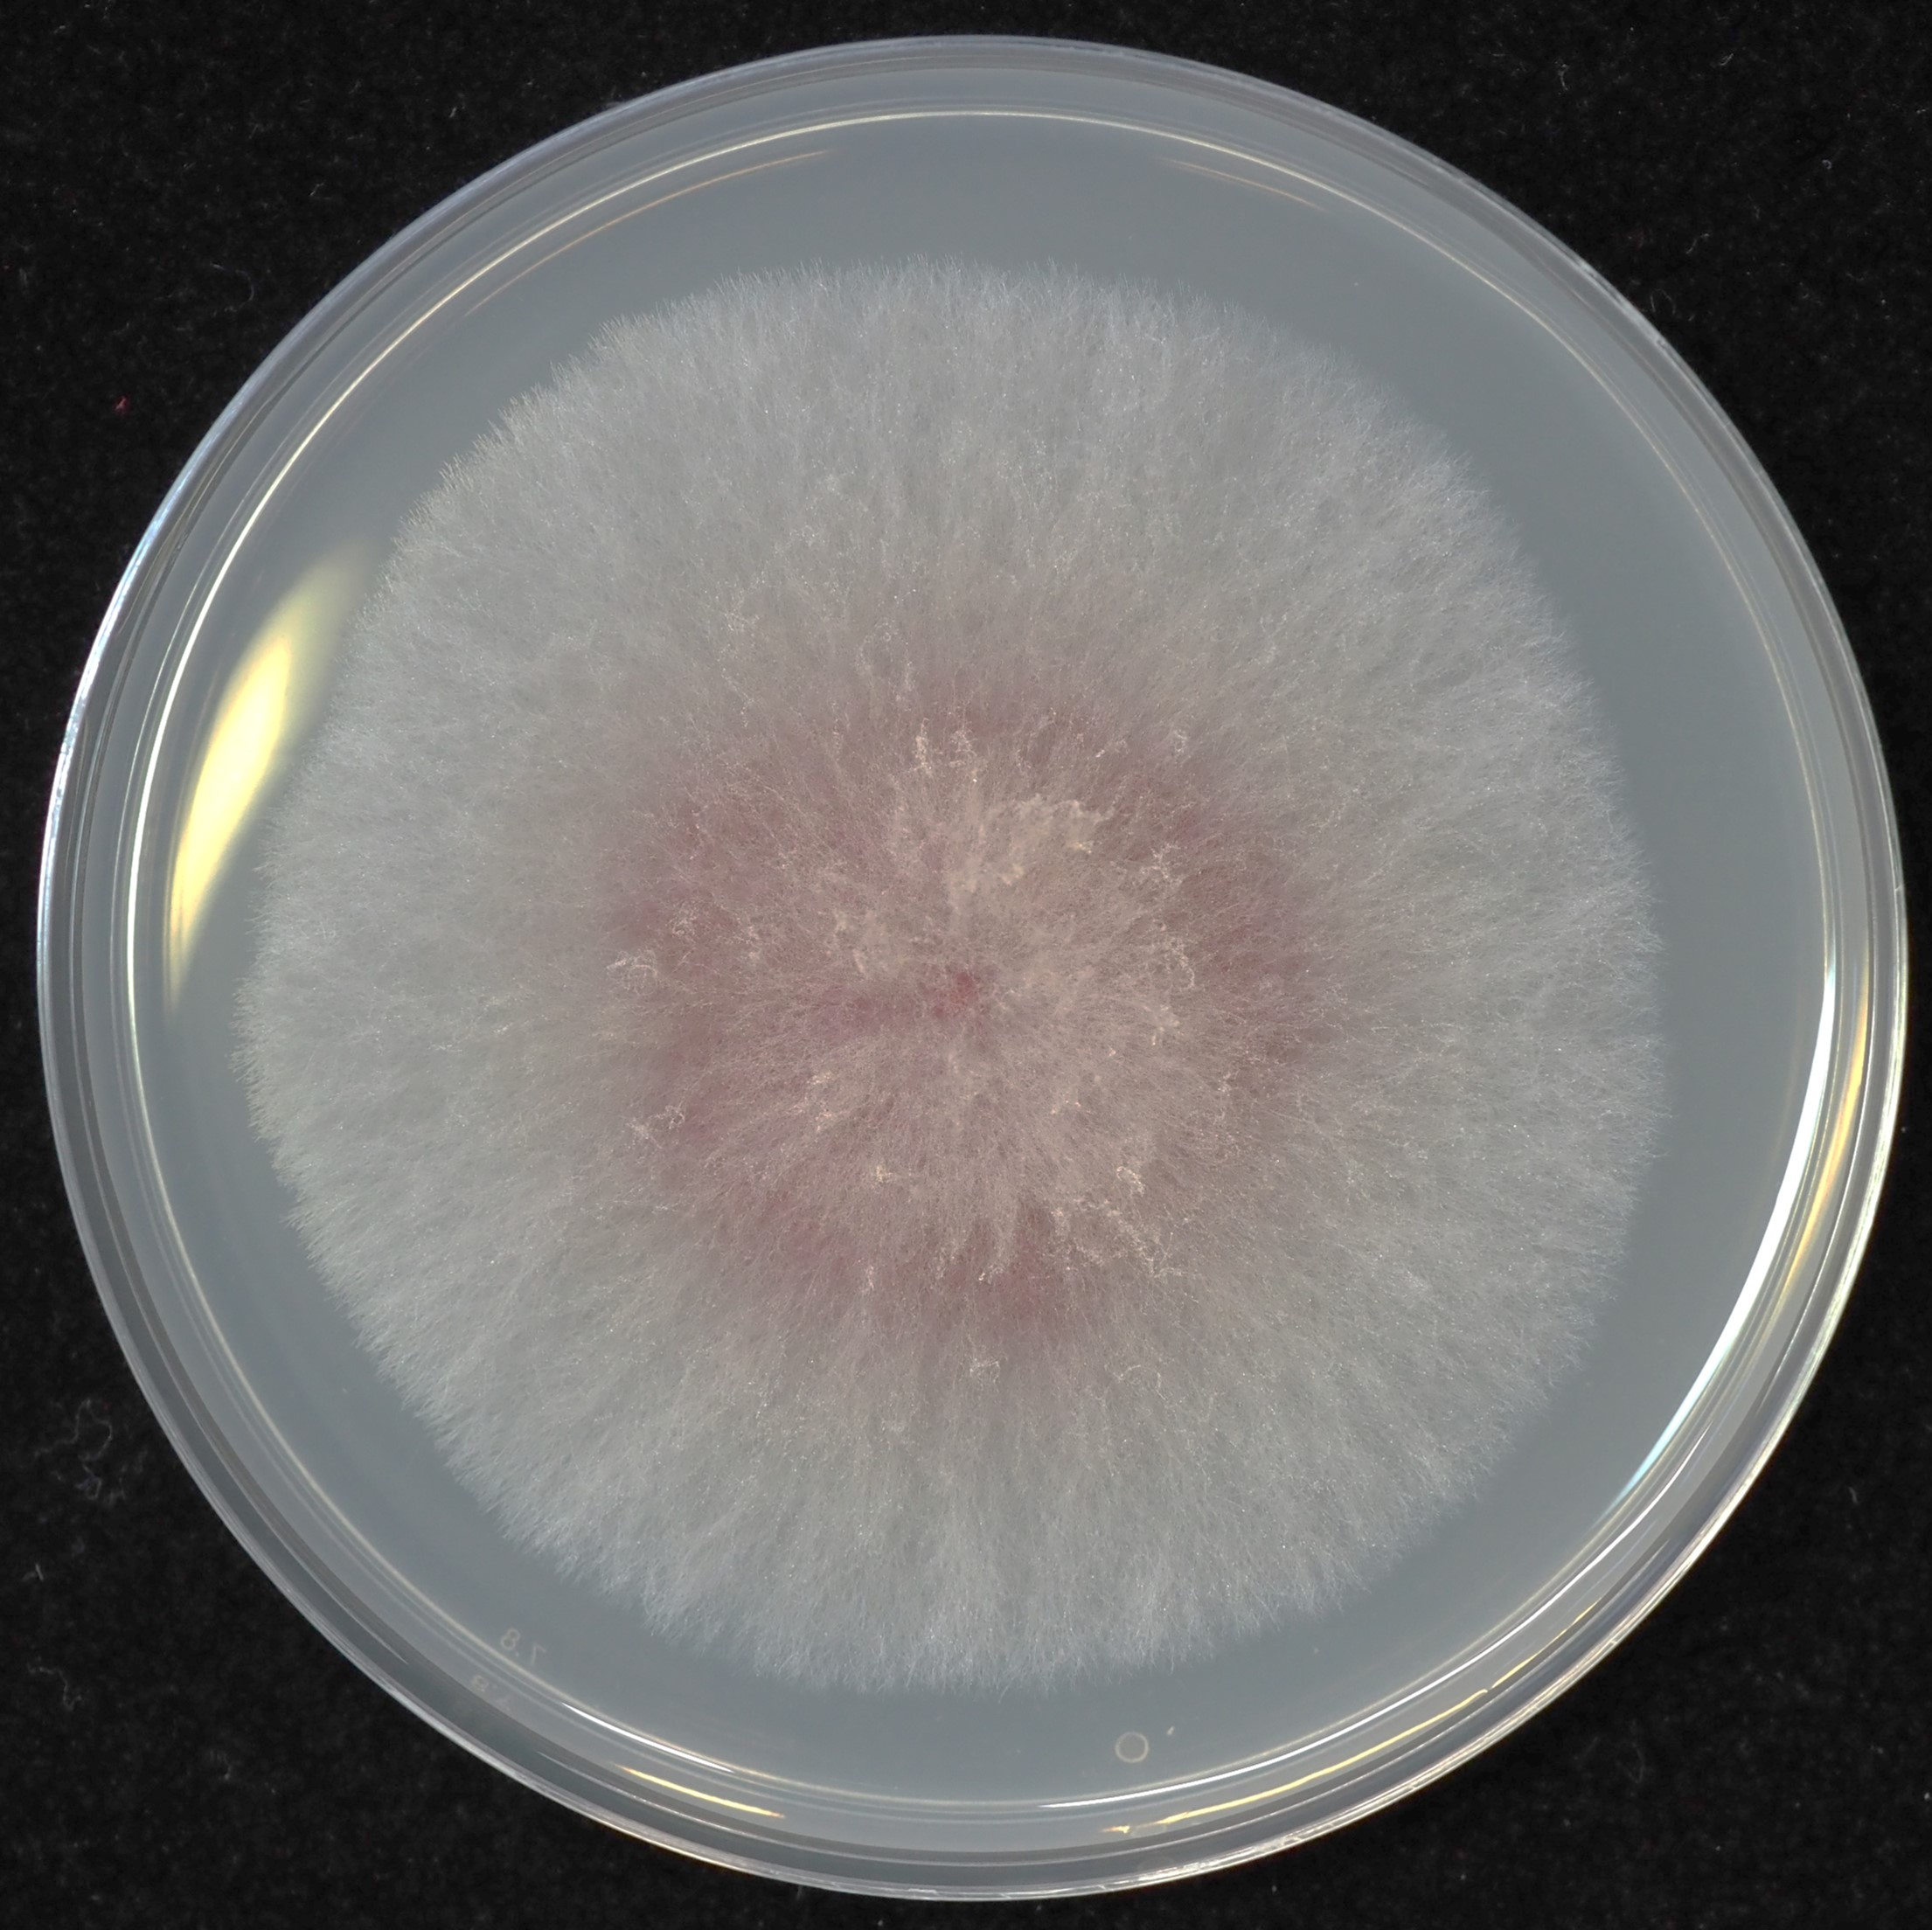
Leucine auxotrophy test of Fusarium graminearum strains

Jan 04, 2024
Leucine auxotrophy test of Fusarium graminearum strains
- 1Rothamsted Research

Protocol Citation: martin.urban 2024. Leucine auxotrophy test of Fusarium graminearum strains. protocols.io https://dx.doi.org/10.17504/protocols.io.q26g7p47qgwz/v1
License: This is an open access protocol distributed under the terms of the Creative Commons Attribution License, which permits unrestricted use, distribution, and reproduction in any medium, provided the original author and source are credited
Protocol status: Working
We use this protocol and it's working
Created: July 29, 2023
Last Modified: January 05, 2024
Protocol Integer ID: 85679
Keywords: leucine auxotrophy status in fusarium graminearum strain, leucine auxotrophy in fusarium graminearum strain, auxotrophy test of fusarium graminearum, fusarium graminearum strain, assessing leucine auxotrophy, leucine auxotrophy status, fusarium graminearum, auxotrophy test, growth characteristics of these strain, preparing leucine dropout, phenotypes to mutant strain, mutant strain, leucine dropout, strain
Disclaimer
DISCLAIMER – FOR INFORMATIONAL PURPOSES ONLY; USE AT YOUR OWN RISK
The protocol content here is for informational purposes only and does not constitute legal, medical, clinical, or safety advice, or otherwise; content added to protocols.io is not peer reviewed and may not have undergone a formal approval of any kind. Information presented in this protocol should not substitute for independent professional judgment, advice, diagnosis, or treatment. Any action you take or refrain from taking using or relying upon the information presented here is strictly at your own risk. You agree that neither the Company nor any of the authors, contributors, administrators, or anyone else associated with protocols.io, can be held responsible for your use of the information contained in or linked to this protocol or any of our Sites/Apps and Services.
Abstract
This protocol outlines the methodology for preparing Leucine dropout medium, essential for assessing Leucine auxotrophy in Fusarium graminearum strains. The procedure involves the step-by-step preparation of the medium to selectively evaluate the growth characteristics of these strains. Understanding the Leucine auxotrophy status in Fusarium graminearum strains holds significance in elucidating their metabolic pathways or assign phenotypes to mutant strains.
Testing Fusarium graminearum strains for Leucine Auxotrophy
Media and supplements:
- Biotin (Supplier: Fluka/Merck)
Biotin is essential for robust growth, particularly beneficial for vivid photography on minimal
medium.
Procedure:
- Dissolve in water to achieve a 0.05% solution.
- Add 20 µl of the 0.05% Biotin stock to 400 ml agar.
Biotin, while not strictly necessary for growth. leads to more vigorous growth, facilitating better photography of the mycelic growth. There might be a role for biotin in the initial steps of glucose metabolism (see references: STRIGINI, P., MORPURGO, G. (1961) and Wu, P.-C., et al. (2020)).
2. Yeast Nitrogen Base (Formedium, CYN0202)
This complete medium is used for routine growth of all strains before the auxotrophy test.
3. Synthetic complete (Kaiser) Drop-out: -LEU (supplier: Formedium, Ref no: DSCK052)
This is the test medium.
4. L-Leucine (supplier Formedium, Ref no: DOC0155)
Procedure:
- Dissolve 1.312 g L-Leucine in 1 M HCL to produce a 1 M stock solution of L-Leucine.
Preparation for 400 ml YNB agar and the Kaiser Drop-out agar with and without Leucine
Medium Composition:
- Yeast Nitrogen Base (YNB): 1.76 g (contains all essential aminoacids)
- Kaiser Drop-out: -LEU: 2.76 g (contains all aminoacids but not Leucine)
- 2% agar
Procedure:
- Weigh YNB and Kaiser Drop-out medium into two 500 ml Schott glass media bottles,
and add 8 g agar.
- Add 400 ml deionised water and autoclave for 15 minutes.
- After autoclaving, cool agar to 50 C.
- Pour YNB medium into agar plates
- For the Kaiser Drop-out medium, add 20 ul 0.05% Biotin stock to 400 ml agar and mix.
- Divide the 400 ml agar into two 200 ml aliquots using sterile Schott glas bottles.
- Pour one aliquot into agar plates to produce the Leucine drop-out medium.
- For the remaining 200 ml aliquot, add 400 ul 1M L-Leucine to 200 ml agar to produce a medium containing 2 mM Leucine.
Growth test of Fusarium graminearum strains
F. graminearum strains are first grown on YNB agar. Small agar plugs (3 x 3 mm2) taken from the actively growing end of the colony are then transferred on agar plates with Kaiser Drop-out medium with and without added Leucine. Plates are incubated at 25 C and growth is assessed after 5 days.
